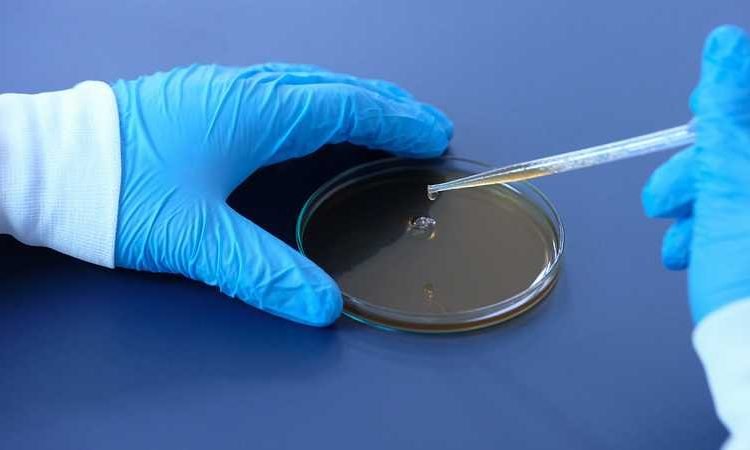
DCGI issues guidelines for manufacturing coronavirus vaccination

By Health In Five Writer
The primary focus in the pharmaceutical industry right now is finding a vaccines for the novel coronavirus. Majority of the nations around the world are looking for a solution to this pandemic and as soon as possible.
The Drugs Controller General of India (DCGI) has now issued a new set of guidelines, focusing on safety, immunogenicity and efficacy parameters for pharma companies involved in developing COVID-19 vaccines.

The DCGI has said that a COVID-19 vaccine candidate should have at least 50 per cent of efficacy in the Phase-III clinical trial for it to be widely deployed and adequate data informing the potential risk of vaccine-associated Enhanced Respiratory Disease (ERD) needs to be generated.
The comprehensive draft regulator guideline for the development of a vaccine with special consideration for the coronavirus vaccine provides guidance to the vaccine developers to ensure that vaccines are well-characterised and manufactured consistently.
The Covid-19 toll in India has already crossed 5.82 million in India with the addition of 86,508 cases on Friday (September 25) with over 92,290 deaths in India so far.
The guidance reads that considering the urgent need for a safe and effective vaccine for prevention of COVID-19, clinical development programs of the COVID-19 vaccine may proceed through an adaptive and seamless approach including data to inform the potential risk of vaccine-associated ERD will be needed.
The document has highlighted that the use of COVID-19 preventive vaccines in pregnancy and in women of childbearing potential is an important consideration for vaccination programs.
“There are three things for a vaccine–(i) the safety, (ii) immunogenicity, and (iii) the efficacy. Even, WHO says that if we can get more than 50 per cent efficacy that is an accepted vaccine. For respiratory viruses, we never get 100 per cent efficacy. We are aiming for 100 per cent efficacy but may get 50-100 per cent,” Dr Balram Bhargava, ICMR, Director-General was quoted as saying by Economic Times, while responding to a query on the efficacy of COVID-19 vaccine.
Dr Bhargava answered in view of the draft guidelines published by the Central Drugs Standard Control Organisation (CDSCO) for the development of a vaccine with special consideration for the COVID-19 vaccine.
The draft guidelines further say that the pharma companies for a statistical final analysis plan finalised before closing the trial database and unblinking treatment assignments (if these were blinded).
“This should include any planned interim analyses, which should be adequately addressed in terms of purpose, timing, and any statistical adjustments required.”